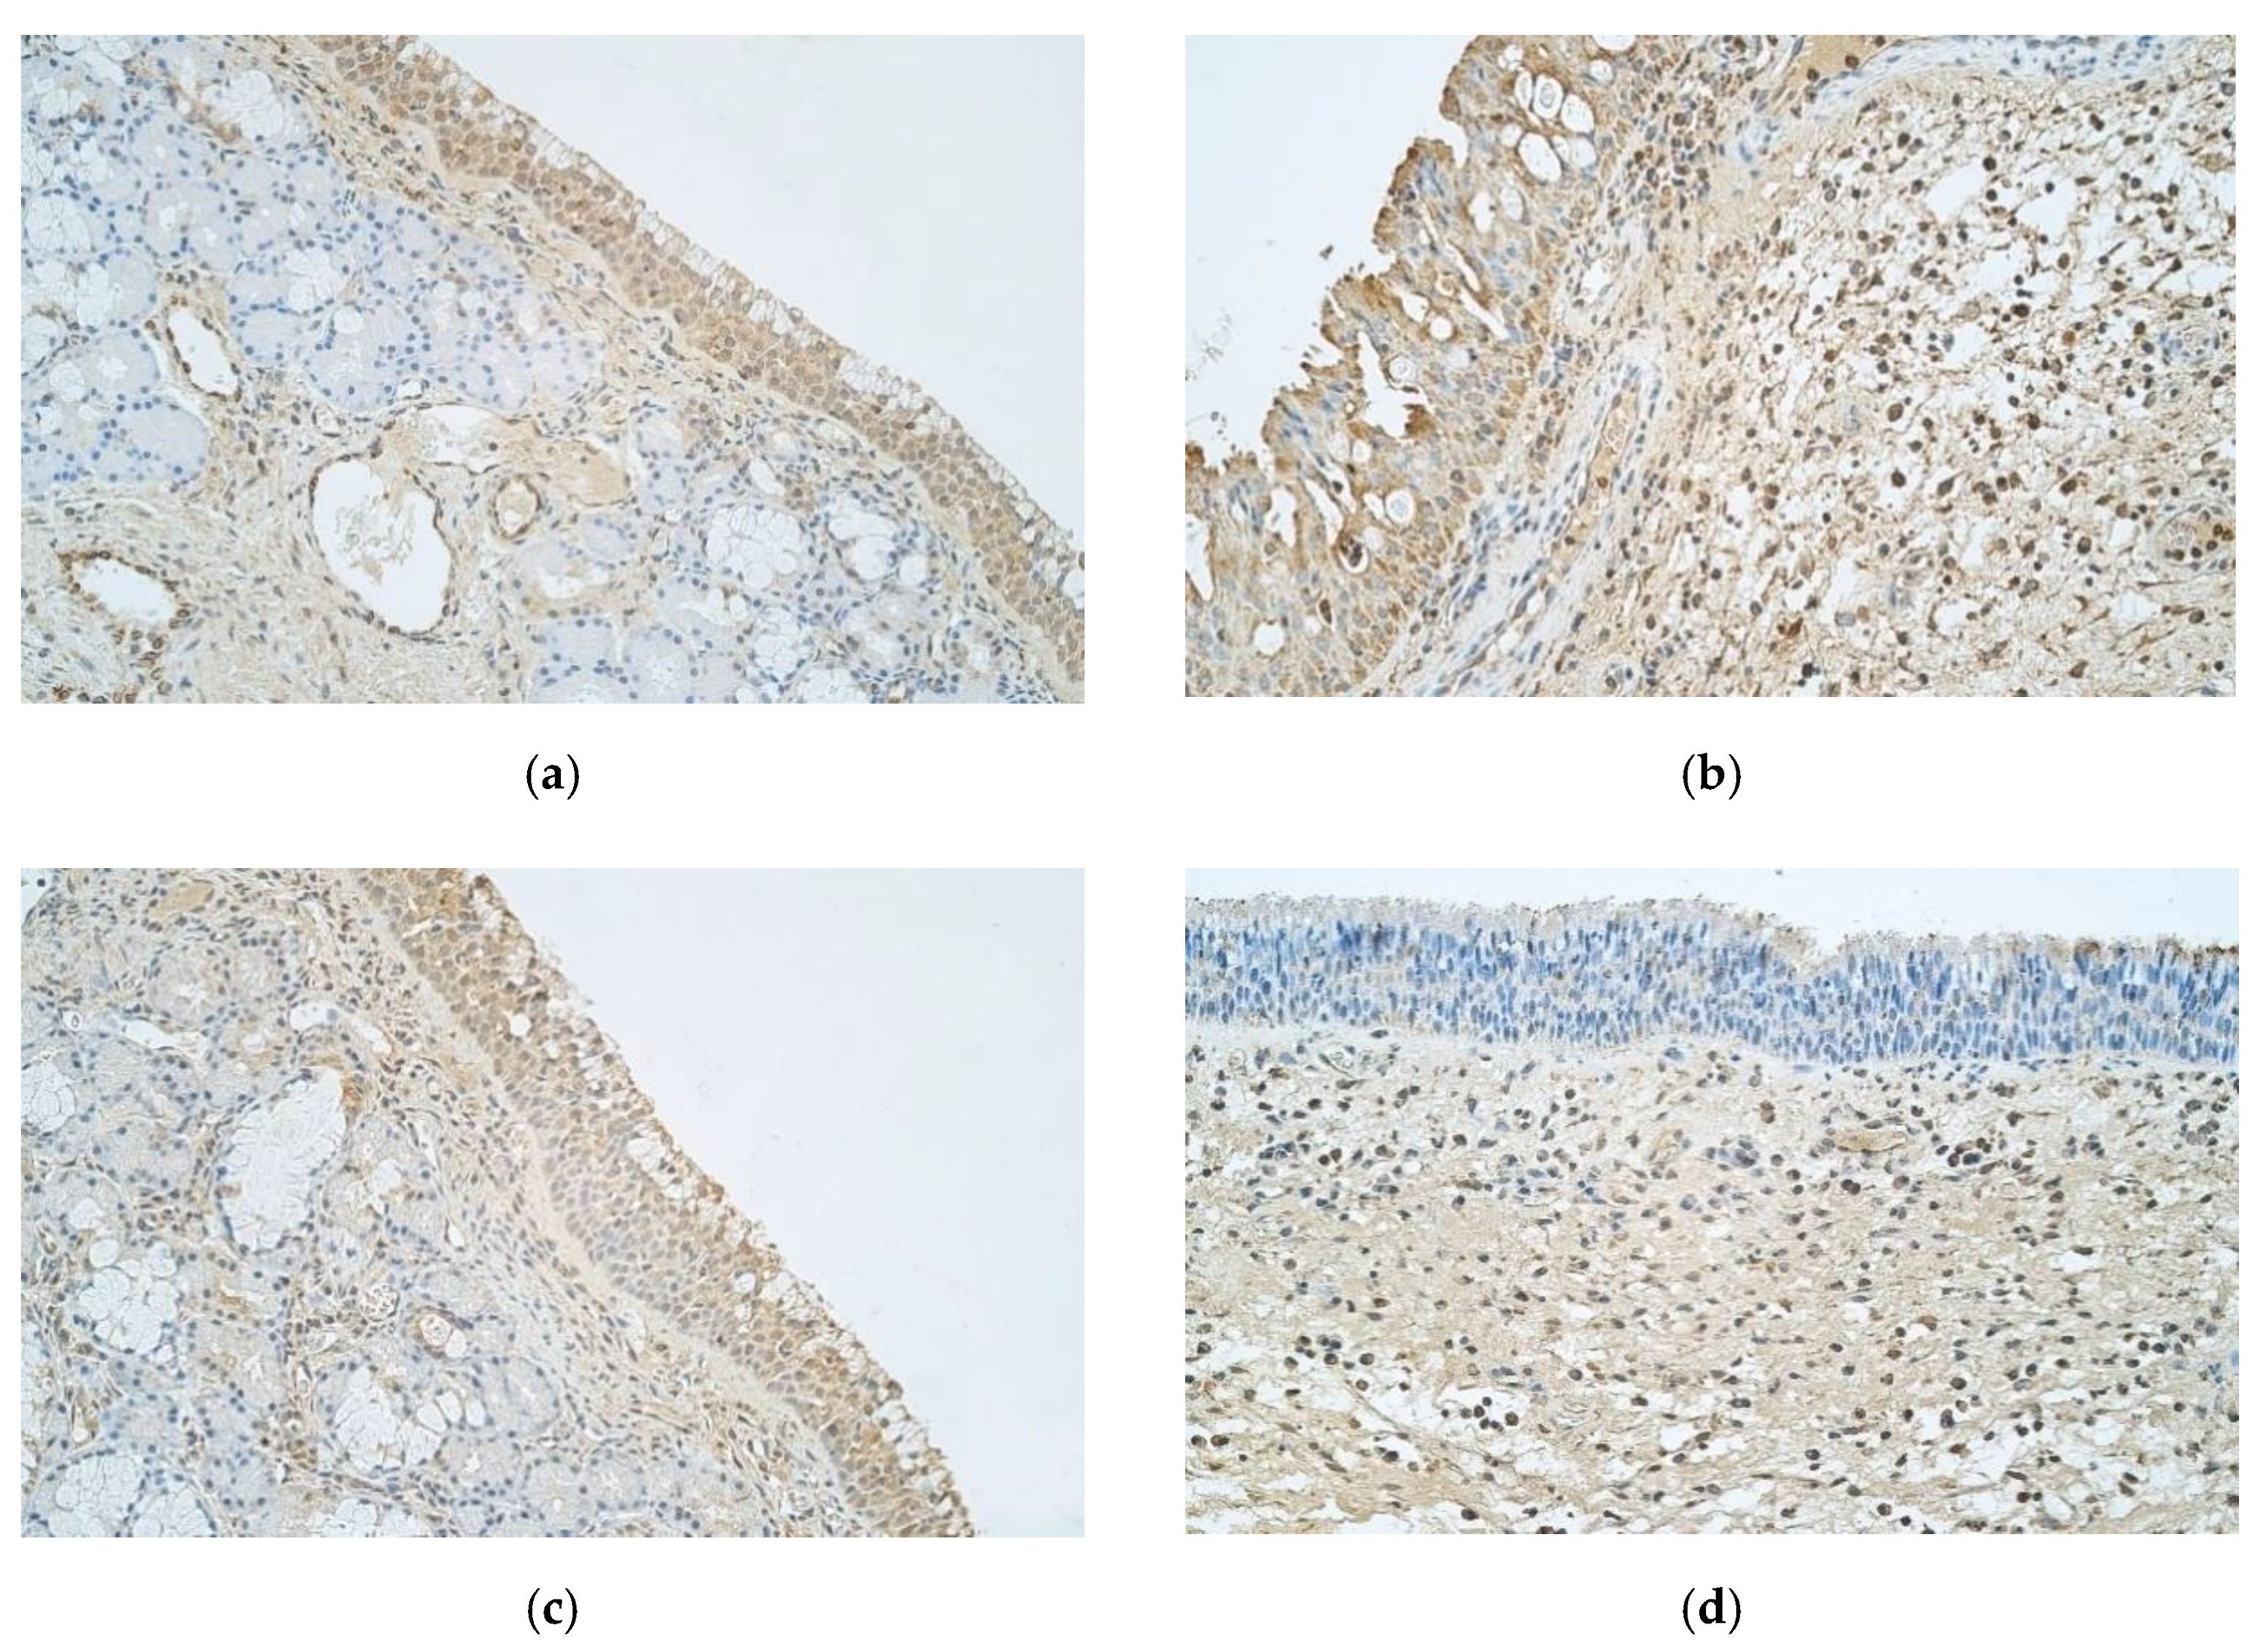
Medicina 57 00607 g003 Medicina 57 00607 g003

Characterization of Cytokines and Proliferation Marker Ki67 in Chronic Rhinosinusitis with Nasal Polyps: A Pilot Study
Abstract
1. Introduction
2. Materials and Methods
2.1. Subject Characteristics
2.2. Immunohistochemical Analysis
2.3. Statistical Analysis
3. Results
4. Discussion
5. Conclusions
Author Contributions
Funding
Institutional Review Board Statement
Informed Consent Statement
Data Availability Statement
Conflicts of Interest
References
- Hastan, D.; Fokkens, W.J.; Bachert, C.; Newson, R.B.; Bislimovska, J.; Bockelbrink, A.; Bousquet, P.J.; Brozek, G.; Bruno, A.; Dahlén, S.E.; et al. Chronic rhinosinusitis in Europe—An underestimated disease. A GA2LEN study. Allergy 2011, 66, 1216–1223. [Google Scholar] [CrossRef]
- Fokkens, W.J.; Lund, V.J.; Hopkins, C.; Hellings, P.W.; Kern, R.; Reitsma, S.; Toppila-Salmi, S.; Bernal-Sprekelsen, M.; Mullol, J. Executive summary of EPOS 2020 including integrated care pathways. Rhin 2020, 58, 82–111. [Google Scholar] [CrossRef]
- Bhattacharyya, N. Contemporary Assessment of the Disease Burden of Sinusitis. Allergy Rhinol. 2009, 23, 392–395. [Google Scholar] [CrossRef] [PubMed]
- Vennik, J.; Eyles, C.; Thomas, M.; Hopkins, C.; Little, P.; Blackshaw, H.; Schilder, A.; Savage, I.; Philpott, C.M. Chronic rhinosinusitis: A qualitative study of patient views and experiences of current management in primary and secondary care. BMJ Open 2019, 9, e022644. [Google Scholar] [CrossRef]
- Stevens, W.W.; Schleimer, R.P.; Kern, R.C. Chronic Rhinosinusitis with Nasal Polyps. J. Allergy Clin. Immunol. Pract. 2016, 4, 565–572. [Google Scholar] [CrossRef]
- Hopkins, C. Chronic Rhinosinusitis with Nasal Polyps. N. Engl. J. Med. 2019, 381, 55–63. [Google Scholar] [CrossRef] [PubMed]
- Hamilos, D.L. Pediatric Chronic Rhinosinusitis. Am. J. Rhinol. Allergy. 2015, 29, 414–420. [Google Scholar] [CrossRef]
- Hsu, D.W.; Suh, J.D. Rhinitis and Sinusitis in the Geriatric Population. Otolaryngol. Clin. N. Am. 2018, 51, 803–813. [Google Scholar] [CrossRef] [PubMed]
- Liao, B.; Liu, J.-X.; Li, Z.-Y.; Zhen, Z.; Cao, P.-P.; Yao, Y.; Long, X.-B.; Wang, H.; Wang, Y.; Schleimer, R.; et al. Multidimensional endotypes of chronic rhinosinusitis and their association with treatment outcomes. Allergy 2018, 73, 1459–1469. [Google Scholar] [CrossRef]
- Tomassen, P.; Vandeplas, G.; Van Zele, T.; Cardell, L.-O.; Arebro, J.; Olze, H.; Förster-Ruhrmann, U.; Kowalski, M.L.; Olszewska-Ziąber, A.; Holtappels, G.; et al. Inflammatory endotypes of chronic rhinosinusitis based on cluster analysis of biomarkers. J. Allergy Clin. Immunol. 2016, 137, 1449–1456.e4. [Google Scholar] [CrossRef] [PubMed]
- Turner, J.H.; Chandra, R.K.; Li, P.; Bonnet, K.; Schlundt, D.G. Identification of clinically relevant chronic rhinosinusitis endotypes using cluster analysis of mucus cytokines. J. Allergy Clin. Immunol. 2018, 141, 1895–1897.e7. [Google Scholar] [CrossRef] [PubMed]
- Wei, B.; Liu, F.; Zhang, J.; Liu, Y.; Du, J.; Liu, S.; Zhang, N.; Bachert, C.; Meng, J. Multivariate analysis of inflammatory endotypes in recurrent nasal polyposis in a Chinese population. Rhinol. J. 2018, 56, 216–226. [Google Scholar] [CrossRef]
- Allen, J.S.; Eisma, R.; Leonard, G.; LaFreniere, D.; Kreutzer, D. Interleukin-8 expression in human nasal polyps. Otolaryngol. Neck Surg. 1997, 117, 535–541. [Google Scholar] [CrossRef]
- Bequignon, E.; Mangin, D.; Bécaud, J.; Pasquier, J.; Angely, C.; Bottier, M.; Escudier, E.; Isabey, D.; Filoche, M.; Louis, B.; et al. Pathogenesis of chronic rhinosinusitis with nasal polyps: Role of IL-6 in airway epithelial cell dysfunction. J. Transl. Med. 2020, 18, 1–12. [Google Scholar] [CrossRef]
- Marseglia, G.L.; Caimmi, S.; Marseglia, A.; Poddighe, D.; Leone, M.; Caimmi, D.; Ciprandi, G.; Castellazzi, A.M. Rhinosinusitis and asthma. Int. J. Immunopathol. Pharmacol. 2010, 23 (Suppl. 1), 29–31. [Google Scholar]
- DeConde, A.S.; Mace, J.C.; Levy, J.M.; Rudmik, L.; Alt, J.A.; Smith, T.L. Prevalence of polyp recurrence after endoscopic sinus surgery for chronic rhinosinusitis with nasal polyposis: Polyp Recurrence After ESS. Laryngoscope 2017, 127, 550–555. [Google Scholar] [CrossRef]
- Soyka, M.B.; Wawrzyniak, P.; Eiwegger, T.; Holzmann, D.; Treis, A.; Wanke, K.; Kast, J.I.; Akdis, C.A. Defective epithelial barrier in chronic rhinosinusitis: The regulation of tight junctions by IFN-γ and IL-4. J. Allergy Clin. Immunol. 2012, 130, 1087–1096.e10. [Google Scholar] [CrossRef] [PubMed]
- Garlanda, C.; Dinarello, C.A.; Mantovani, A. The Interleukin-1 Family: Back to the Future. Immunity 2013, 39, 1003–1018. [Google Scholar] [CrossRef]
- Malik, A.; Kanneganti, T.-D. Function and regulation of IL-1α in inflammatory diseases and cancer. Immunol. Rev. 2018, 281, 124–137. [Google Scholar] [CrossRef] [PubMed]
- Di Paolo, N.C.; Shayakhmetov, D.M. Interleukin 1α and the inflammatory process. Nat. Immunol. 2016, 17, 906–913. [Google Scholar] [CrossRef]
- Steinke, J.W.; Borish, L. Cytokines in Allergic Inflammation. In Middleton’s Allergy: Principles and Practice: Ninth Edition; Burks, B., Holgate, S.T., O’Hehir, R.E., Bacharier, L.B., Broide, D.H., Khurana Hershey, G.K., Peebles, S., Eds.; Elsevier: Amsterdam, The Netherlands, 2020; Volume 1, pp. 65–80. [Google Scholar]
- Kato, A. Immunopathology of chronic rhinosinusitis. Allergol. Int. 2015, 64, 121–130. [Google Scholar] [CrossRef] [PubMed]
- Gandhi, N.A.; Pirozzi, G.; Graham, N.M.H. Commonality of the IL-4/IL-13 pathway in atopic diseases. Expert Rev. Clin. Immunol. 2017, 13, 425–437. [Google Scholar] [CrossRef] [PubMed]
- Kimura, A.; Kishimoto, T. IL-6: Regulator of Treg/Th17 balance. Eur. J. Immunol. 2010, 40, 1830–1835. [Google Scholar] [CrossRef]
- Rose-John, S.; Winthrop, K.; Calabrese, L. The role of IL-6 in host defence against infections: Immunobiology and clinical implications. Nat. Rev. Rheumatol. 2017, 13, 399–409. [Google Scholar] [CrossRef]
- Kelly, E.A.B.; Koziol-White, C.J.; Clay, K.J.; Liu, L.Y.; Bates, M.E.; Bertics, P.J.; Jarjour, N.N. Potential Contribution of IL-7 to Allergen-Induced Eosinophilic Airway Inflammation in Asthma. J. Immunol. 2009, 182, 1404–1410. [Google Scholar] [CrossRef]
- Baggiolini, M.; Clark-Lewis, I. Interleukin-8, a chemotactic and inflammatory cytokine. FEBS Lett. 1992, 307, 97–101. [Google Scholar] [CrossRef]
- Rutz, S.; Ouyang, W. Regulation of Interleukin-10 Expression. Adv. Exp. Med. Biol. 2016, 941, 89–116. [Google Scholar] [CrossRef] [PubMed]
- Trinchieri, G. Interleukin-12 and the regulation of innate resistance and adaptive immunity. Nat. Rev. Immunol. 2003, 3, 133–146. [Google Scholar] [CrossRef]
- Sun, X.; Kaufman, P.D. Ki-67: More than a proliferation marker. Chromosoma 2018, 127, 175–186. [Google Scholar] [CrossRef]
- Gerdes, J.; Lemke, H.; Baisch, H.; Wacker, H.H.; Schwab, U.; Stein, H. Cell cycle analysis of a cell proliferation-associated human nuclear antigen defined by the monoclonal antibody Ki-67. J. Immunol. 1984, 133. [Google Scholar]
- Chalastras, T.; Athanassiadou, P.; Patsouris, E.; Eleftheriadou, A.; Kandiloros, D.; Papaxoinis, K.; Nicolopoulou-Stamati, P. Differential rates of proliferation and apoptosis in nasal polyps correspond to alterations in DNA spatial distribution and nuclear polarization as observed by confocal microscopy. Eur. Arch. Oto-Rhino-Laryngol. 2009, 267, 1075–1080. [Google Scholar] [CrossRef]
- Pilmane, M.; Sidhoma, E.; Akota, I.; Kazoka, D. Characterization of Cytokines and Proliferation Marker Ki67 in Cleft Affected Lip Tissue. Medicina 2019, 55, 518. [Google Scholar] [CrossRef] [PubMed]
- Prion, S.; Haerling, K.A. Making Sense of Methods and Measurement: Spearman-Rho Ranked-Order Correlation Coefficient. Clin. Simul. Nurs. 2014, 10, 535–536. [Google Scholar] [CrossRef]
- Greenland, S.; Senn, S.J.; Rothman, K.J.; Carlin, J.B.; Poole, C.; Goodman, S.N. Statistical tests, P values, confidence intervals, and power: A guide to misinterpretations. Eur. J. Epidemiol. 2016, 31, 337–350. [Google Scholar] [CrossRef]
- Aydın, Ü.; Şentürk, A.T.; Durmaz, A.; Tosun, F. An evaluation of histopathological changes in ethmoid sinus mucosa after endoscopic sinus surgery. Kulak Burun Bogaz Ihtis Derg 2013, 23, 319–324. [Google Scholar] [CrossRef]
- Wang, X.; Wong, K.; Ouyang, W.; Rutz, S. Targeting IL-10 Family Cytokines for the Treatment of Human Diseases. Cold Spring Harb. Perspect. Biol. 2019, 11, a028548. [Google Scholar] [CrossRef]
- Wise, S.K.; Laury, A.M.; Katz, E.H.; Den Beste, K.A.; Parkos, C.A.; Nusrat, A. Interleukin-4 and interleukin-13 compromise the sinonasal epithelial barrier and perturb intercellular junction protein expression: IL-4 and IL-13 Effect on Sinus Epithelial Barrier. Int. Forum Allergy Rhinol. 2014, 4, 361–370. [Google Scholar] [CrossRef]
- Steinke, J.W. Anti–interleukin-4 therapy. Immunol. Allergy Clin. N. Am. 2004, 24, 599–614. [Google Scholar] [CrossRef]
- Miłoński, J.; Zielińska-Bliźniewska, H.; Przybyłowska, K.; Pietkiewicz, P.; Korzycka-Zaborowska, B.; Majsterek, I.; Olszewski, J. Significance of CYCLOOXYGENASE-2(COX-2), PERIOSTIN (POSTN) and INTERLEUKIN-4(IL-4) gene expression in the pathogenesis of chronic rhinosinusitis with nasal polyps. Eur. Arch. Otorhinolaryngol. 2015, 272, 3715–3720. [Google Scholar] [CrossRef]
- Tyler, M.A.; Russell, C.B.; Smith, D.E.; Rottman, J.B.; Dietz, C.J.P.; Hu, X.; Citardi, M.J.; Fakhri, S.; Assassi, S.; Luong, A. Large-scale gene expression profiling reveals distinct type 2 inflammatory patterns in chronic rhinosinusitis subtypes. J. Allergy Clin. Immunol. 2017, 139, 1061–1064.e4. [Google Scholar] [CrossRef]
- Mazzucchelli, R.; Durum, S.K. Interleukin-7 receptor expression: Intelligent design. Nat. Rev. Immunol. 2007, 7, 144–154. [Google Scholar] [CrossRef]
- Yoon, B.-N.; Choi, N.-G.; Lee, H.-S.; Cho, K.-S.; Roh, H.-J. Induction of Interleukin-8 from Nasal Epithelial Cells during Bacterial Infection: The Role of IL-8 for Neutrophil Recruitment in Chronic Rhinosinusitis. Mediat. Inflamm. 2010, 2010, 1–7. [Google Scholar] [CrossRef]
- Li Jeon, N.; Baskaran, H.; Dertinger, S.K.W.; Whitesides, G.M.; Van De Water, L.; Toner, M. Neutrophil chemotaxis in linear and complex gradients of interleukin-8 formed in a microfabricated device. Nat. Biotechnol. 2002, 20, 826–830. [Google Scholar] [CrossRef] [PubMed]
- Xu, J.; Han, R.; Kim, D.W.; Mo, J.-H.; Jin, Y.; Rha, K.-S.; Kim, Y.M. Role of Interleukin-10 on Nasal Polypogenesis in Patients with Chronic Rhinosinusitis with Nasal Polyps. PLoS ONE 2016, 11, e0161013. [Google Scholar] [CrossRef]
- Schwartz, J.; Al-Mot, S.; Endam, M.; Alromaih, S.; Madrenas, J.; Desrosiers, M. Bacterial immune evasion via an IL-10 mediated host response, a novel pathophysiologic mechanism for chronic rhinosinusitis. Rhinol. J. 2017, 55, 227–233. [Google Scholar] [CrossRef]
- Wang, Z.-C.; Yao, Y.; Wang, N.; Liu, J.-X.; Ma, J.; Chen, C.-L.; Deng, Y.K.; Wang, M.C.; Liu, Y.; Zhang, X.H.; et al. Deficiency in interleukin-10 production by M2 macrophages in eosinophilic chronic rhinosinusitis with nasal polyps: IL-10 + M2 macrophages in CRSwNP. Int. Forum Allergy Rhinol. 2018, 8, 1323–1333. [Google Scholar] [CrossRef] [PubMed]
- Haruna, T.; Kariya, S.; Fujiwara, T.; Higaki, T.; Makihara, S.; Kanai, K.; Fujiwara, R.; Iwasaki, S.; Noguchi, Y.; Nishizaki, K.; et al. Association between impaired IL-10 production following exposure to Staphylococcus aureus enterotoxin B and disease severity in eosinophilic chronic rhinosinusitis. Allergol. Int. 2018, 67, 392–398. [Google Scholar] [CrossRef]
- Kassim, S.K.; Elbeigermy, M.; Nasr, G.F.; Khalil, R.; Nassar, M. The role of interleukin-12, and tissue antioxidants in chronic sinusitis. Clin. Biochem. 2002, 35, 369–375. [Google Scholar] [CrossRef]
- Wright, E.D.; Christodoulopoulos, P.; Frenkiel, S.; Hamid, Q. Expression of interleukin (IL)-12 (p40) and IL-12 (beta2) receptors in allergic rhinitis and chronic sinusitis. Clin. Exp. Allergy 1999, 29, 1320–1325. [Google Scholar] [CrossRef]
- Deng, H.; Sun, Y.; Wang, W.; Li, M.; Yuan, T.; Kong, W.; Huang, X.; Long, Z.; Chen, Z.; Wang, D.; et al. The hippo pathway effector Yes-associated protein promotes epithelial proliferation and remodeling in chronic rhinosinusitis with nasal polyps. Allergy 2019, 74, 731–742. [Google Scholar] [CrossRef]
- Kim, D.-K.; Lim, H.-S.; Eun, K.; Seo, Y.; Kim, J.; Kim, Y.; Kim, M.-K.; Jin, S.; Han, S. Subepithelial neutrophil infiltration as a predictor of the surgical outcome of chronic rhinosinusitis with nasal polyps. Rhinol. J. 2020, 1. [Google Scholar] [CrossRef]
- Rha, M.-S.; Kim, S.-W.; Chang, D.-Y.; Lee, J.-K.; Kim, J.; Park, S.-H.; Khalmuratova, R.; Lim, H.-S.; Eun, K.M.; Hong, S.-N.; et al. Superantigen-related TH2 CD4+ T cells in nonasthmatic chronic rhinosinusitis with nasal polyps. J. Allergy Clin. Immunol. 2020, 145, 1378–1388.e10. [Google Scholar] [CrossRef]
- Razi Soofiyani, S.; Kazemi, T.; Lotfipour, F.; Mohammad Hosseini, A.; Shanehbandi, D.; Hallaj-Nezhadi, S.; Baradaran, B. Gene therapy with IL-12 induced enhanced anti-tumor activity in fibrosarcoma mouse model. Artif. Cells Nanomed. Biotechnol. 2016, 44, 1988–1993. [Google Scholar] [CrossRef] [PubMed]
- Bradley, D.T.; Kountakis, S.E. Role of Interleukins and Transforming Growth Factor-β in Chronic Rhinosinusitis and Nasal Polyposis. Laryngoscope 2005, 115, 684–686. [Google Scholar] [CrossRef] [PubMed]
- Poddighe, D.; Vangelista, L. Staphylococcus aureus Infection and Persistence in Chronic Rhinosinusitis: Focus on Leukocidin ED. Toxins 2020, 12, 678. [Google Scholar] [CrossRef]
- Ryu, G.; Kim, D.W. Th2 inflammatory responses in the development of nasal polyps and chronic rhinosinusitis. Curr. Opin. Allergy Clin. Immunol. 2020, 20, 1–8. [Google Scholar] [CrossRef]
- Fujieda, S.; Imoto, Y.; Kato, Y.; Ninomiya, T.; Tokunaga, T.; Tsutsumiuchi, T.; Yoshida, K.; Kidoguchi, M.; Takabayashi, T. Eosinophilic chronic rhinosinusitis. Allergol. Int. 2019, 68, 403–412. [Google Scholar] [CrossRef]
- Poddighe, D.; Brambilla, I.; Licari, A.; Marseglia, G.L. Pediatric rhinosinusitis and asthma. Respir. Med. 2018, 141, 94–99. [Google Scholar] [CrossRef]

| Factors/Subjects | IL-1α | IL-4 | IL-6 | IL-7 | IL-8 | IL-10 | IL-12 | Ki 67 | ||||||||
|---|---|---|---|---|---|---|---|---|---|---|---|---|---|---|---|---|
| E | CT | E | CT | E | CT | E | CT | E | CT | E | CT | E | CT | E | CT | |
| 1 | ++ | +++ | ++ | ++/+++ | ++ | +++ | ++ | +++ | ++ | +++ | ++ | +++ | ++/+++ | +++ | + | + |
| 2 | +++ | +++ | ++ | ++/+++ | ++ | ++/+++ | + | ++ | ++ | ++ | +++ | +++ | ++ | +++ | +/++ | + |
| 3 | ++ | ++ | + | ++ | + | +++ | ++ | +++ | +/++ | ++ | ++ | +++ | + | +++ | ++ | + |
| 4 | 0/+ | ++ | + | ++ | ++ | +++ | ++ | ++ | ++ | ++ | ++/+++ | +++ | ++/+++ | +++ | 0/+ | 0/+ |
| 5 | 0/+ | +/++ | + | 0/+ | 0 | + | ++ | 0/+ | ||||||||
| 6 | + | +/++ | + | + | + | +/++ | + | ++/+++ | 0/+ | + | + | + | ++ | +++ | 0 | + |
| 7 | +/++ | ++/+++ | +/++ | +++ | + | +++ | +/++ | +++ | 0 | + | 0 | 0/+ | ++ | ++/+++ | ++ | + |
| 8 | ++ | ++ | + | ++ | +/++ | ++/+++ | +/++ | ++ | + | + | +/++ | +/++ | +++ | ++ | 0 | 0 |
| 9 | + | + | ++ | + | + | + | + | 0 | ||||||||
| 10 | + | + | + | ++/+++ | + | ++/+++ | + | ++/+++ | 0 | + | + | +/++ | ++ | +++ | ++ | + |
| 11 | 0/+ | + | + | ++/+++ | ++ | +++ | +/++ | +++ | + | +/++ | +/++ | ++/+++ | ++ | +++ | +/++ | ++/+++ |
| 12 | 0/+ | +/++ | ++ | ++/+++ | +/++ | ++/+++ | +/++ | ++ | + | + | ++ | ++ | +++ | ++++ | ++ | ++ |
| Average | +/++ | ++ | +/++ | ++ | +/++ | ++/+++ | +/++ | ++ | + | +/++ | +/++ | ++ | ++ | +++ | + | + |
| Control | ++/+++ | 0/+ | +++ | +/++ | +++ | + | +++ | +/++ | +++/++++ | + | ++++ | ++ | +++ | + | +/++ | 0/+ |
| Significant Difference (p-value) | 0.001 | <0.001 | <0.001 | 0.014 | <0.001 | <0.001 | <0.001 | 0.006 | <0.001 | 0.028 | <0.001 | 0.811 | 0.002 | <0.001 | 0.309 | 0.073 |
Publisher’s Note: MDPI stays neutral with regard to jurisdictional claims in published maps and institutional affiliations. |
© 2021 by the authors. Licensee MDPI, Basel, Switzerland. This article is an open access article distributed under the terms and conditions of the Creative Commons Attribution (CC BY) license (https://creativecommons.org/licenses/by/4.0/).
Share and Cite
Viksne, R.J.; Sumeraga, G.; Pilmane, M. Characterization of Cytokines and Proliferation Marker Ki67 in Chronic Rhinosinusitis with Nasal Polyps: A Pilot Study. Medicina 2021, 57, 607. https://doi.org/10.3390/medicina57060607
Viksne RJ, Sumeraga G, Pilmane M. Characterization of Cytokines and Proliferation Marker Ki67 in Chronic Rhinosinusitis with Nasal Polyps: A Pilot Study. Medicina. 2021; 57(6):607. https://doi.org/10.3390/medicina57060607
Chicago/Turabian StyleViksne, Rudolfs Janis, Gunta Sumeraga, and Mara Pilmane. 2021. "Characterization of Cytokines and Proliferation Marker Ki67 in Chronic Rhinosinusitis with Nasal Polyps: A Pilot Study" Medicina 57, no. 6: 607. https://doi.org/10.3390/medicina57060607
APA StyleViksne, R. J., Sumeraga, G., & Pilmane, M. (2021). Characterization of Cytokines and Proliferation Marker Ki67 in Chronic Rhinosinusitis with Nasal Polyps: A Pilot Study. Medicina, 57(6), 607. https://doi.org/10.3390/medicina57060607

